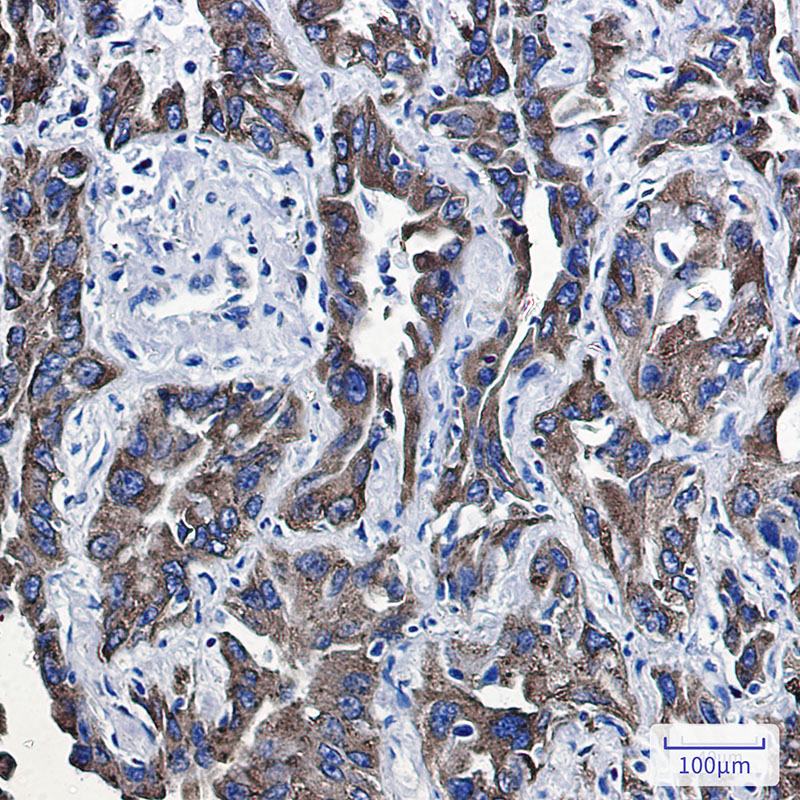
2 - P4HB Rabbit mAb AP75854

P4HB Rabbit mAb
- 产品详情
- 实验流程
- 背景知识
Application
| WB, IHC-P |
|---|---|
| Primary Accession | P07237 |
| Reactivity | Rat, Human, Mouse |
| Host | Rabbit |
| Clonality | Monoclonal Antibody |
| Isotype | IgG |
| Conjugate | Unconjugated |
| Purification | Affinity Purified |
| Calculated MW | 57116 Da |
| Gene ID | 5034 |
|---|---|
| Other Names | P4HB |
| Dilution | WB~~1:1000-1:5000 IHC-P~~1:50~200 |
| Format | Liquid in 50mM Tris-Glycine(pH 7.4), 0.15M NaCl, 40%Glycerol, 0.01% sodium azide and 0.05% BSA. |
| Storage | Store at 4°C short term. Aliquot and store at -20°C long term. Avoid freeze/thaw cycles. |
| Name | P4HB |
|---|---|
| Synonyms | ERBA2L, PDI, PDIA1, PO4DB |
| Function | This multifunctional protein catalyzes the formation, breakage and rearrangement of disulfide bonds. At the cell surface, seems to act as a reductase that cleaves disulfide bonds of proteins attached to the cell. May therefore cause structural modifications of exofacial proteins. Inside the cell, seems to form/rearrange disulfide bonds of nascent proteins. At high concentrations and following phosphorylation by FAM20C, functions as a chaperone that inhibits aggregation of misfolded proteins (PubMed:32149426). At low concentrations, facilitates aggregation (anti-chaperone activity). May be involved with other chaperones in the structural modification of the TG precursor in hormone biogenesis. Also acts as a structural subunit of various enzymes such as prolyl 4-hydroxylase and microsomal triacylglycerol transfer protein MTTP. Receptor for LGALS9; the interaction retains P4HB at the cell surface of Th2 T helper cells, increasing disulfide reductase activity at the plasma membrane, altering the plasma membrane redox state and enhancing cell migration (PubMed:21670307). |
| Cellular Location | Endoplasmic reticulum. Endoplasmic reticulum lumen. Melanosome. Cell membrane; Peripheral membrane protein. Note=Highly abundant. In some cell types, seems to be also secreted or associated with the plasma membrane, where it undergoes constant shedding and replacement from intracellular sources (Probable). Localizes near CD4-enriched regions on lymphoid cell surfaces (PubMed:11181151). Identified by mass spectrometry in melanosome fractions from stage I to stage IV (PubMed:10636893) Colocalizes with MTTP in the endoplasmic reticulum (PubMed:23475612) {ECO:0000269|PubMed:10636893, ECO:0000269|PubMed:11181151, ECO:0000269|PubMed:23475612, ECO:0000305} |
For Research Use Only. Not For Use In Diagnostic Procedures.
Provided below are standard protocols that you may find useful for product applications.
BACKGROUND
This gene encodes the beta subunit of prolyl 4-hydroxylase, a highly abundant multifunctional enzyme that belongs to the protein disulfide isomerase family. When present as a tetramer consisting of two alpha and two beta subunits, this enzyme is involved in hydroxylation of prolyl residues in preprocollagen. This enzyme is also a disulfide isomerase containing two thioredoxin domains that catalyze the formation, breakage and rearrangement of disulfide bonds. Other known functions include its ability to act as a chaperone that inhibits aggregation of misfolded proteins in a concentration-dependent manner, its ability to bind thyroid hormone, its role in both the influx and efflux of S-nitrosothiol-bound nitric oxide, and its function as a subunit of the microsomal triglyceride transfer protein complex.
终于等到您。ABCEPTA(百远生物)抗体产品。
点击下方“我要评价 ”按钮提交您的反馈信息,您的反馈和评价是我们最宝贵的财富之一,
我们将在1-3个工作日内处理您的反馈信息。
如有疑问,联系:0512-88856768 tech-china@abcepta.com.























 癌症的基本特征包括细胞增殖、血管生成、迁移、凋亡逃避机制和细胞永生等。找到癌症发生过程中这些通路的关键标记物和对应的抗体用于检测至关重要。
癌症的基本特征包括细胞增殖、血管生成、迁移、凋亡逃避机制和细胞永生等。找到癌症发生过程中这些通路的关键标记物和对应的抗体用于检测至关重要。 为您推荐一个泛素化位点预测神器——泛素化分析工具,可以为您的蛋白的泛素化位点作出预测和评分。
为您推荐一个泛素化位点预测神器——泛素化分析工具,可以为您的蛋白的泛素化位点作出预测和评分。 细胞自噬受体图形绘图工具为你的蛋白的细胞受体结合位点作出预测和评分,识别结合到自噬通路中的蛋白是非常重要的,便于让我们理解自噬在正常生理、病理过程中的作用,如发育、细胞分化、神经退化性疾病、压力条件下、感染和癌症。
细胞自噬受体图形绘图工具为你的蛋白的细胞受体结合位点作出预测和评分,识别结合到自噬通路中的蛋白是非常重要的,便于让我们理解自噬在正常生理、病理过程中的作用,如发育、细胞分化、神经退化性疾病、压力条件下、感染和癌症。